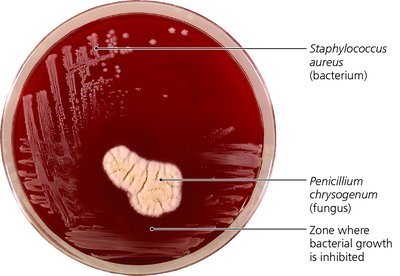
Petri dish showing Penicillium inhibiting Staphylococcus growth

Back
BackControlling Microbial Growth in the Body: Antimicrobial Drugs
Study Guide - Smart Notes

Controlling Microbial Growth in the Body: Antimicrobial Drugs
Introduction to Antimicrobial Drugs
Antimicrobial drugs are essential tools in the treatment of infectious diseases. They include antibiotics, semisynthetic drugs, and synthetic drugs, each with unique origins and mechanisms of action. The effectiveness of these agents relies on their ability to selectively target microbial processes without harming the host.
Antibiotics: Antimicrobials derived from microorganisms (e.g., Penicillium species produce penicillin).
Synthetic drugs: Completely synthesized in laboratories.
Semisynthetic antimicrobials: Chemically modified antibiotics to enhance efficacy or spectrum.
Bactericidal: Agents that kill bacteria.
Bacteriostatic: Agents that inhibit bacterial growth without killing.
Spectrum: The range of organisms an antimicrobial is active against (broad vs. narrow spectrum).
Sources of Common Antibiotics and Semisynthetics
Many antibiotics are derived from fungi and bacteria. The following table summarizes key sources and their representative antimicrobials:
Microorganism | Antimicrobial |
|---|---|
Penicillium chrysogenum | Penicillin G |
Penicillium griseofulvum | Griseofulvin |
Acremonium spp. | Cephalothin |
Amycolatopsis orientalis | Vancomycin |
Bacillus licheniformis | Bacitracin |
Bacillus polymyxa | Polymyxin |
Micromonospora purpurea | Gentamicin |
Streptomyces griseus | Streptomycin |
Streptomyces fradiae | Neomycin |
Streptomyces aureofaciens | Tetracycline |
Streptomyces venezuelae | Chloramphenicol |
Streptomyces nodosus | Amphotericin B |
Mechanisms of Antimicrobial Action
The key to effective antimicrobial therapy is selective toxicity—the drug must target microbial structures or functions not found in the host. The main mechanisms include:
Inhibition of cell wall synthesis
Inhibition of protein synthesis
Disruption of cytoplasmic membranes
Inhibition of metabolic pathways
Inhibition of nucleic acid synthesis
Prevention of virus attachment, entry, or uncoating

Inhibition of Cell Wall Synthesis
Overview
Many bacteria and fungi possess cell walls, which are absent in animal cells. Antimicrobials targeting cell wall synthesis are selectively toxic and cause cell lysis in growing cells by weakening the wall.
Most common agents prevent cross-linkage of N-acetylmuramic acid (NAM) subunits in peptidoglycan.
Beta-lactams (e.g., penicillins, cephalosporins, carbapenems) bind to enzymes that cross-link NAM subunits, leading to cell lysis.

Spectrum of Beta-Lactam Antibiotics
Natural penicillins: Effective mainly against Gram-positive bacteria.
Semisynthetic penicillins: Broader spectrum, including some Gram-negative bacteria.
Cephalosporins: Natural forms are limited; semisynthetic forms have broader action.
Monobactams: Limited to aerobic Gram-negative bacteria.
Other Cell Wall Inhibitors
Bacitracin: Blocks transport of NAG and NAM from the cytoplasm.
Vancomycin and cycloserine: Interfere with bridges linking NAM subunits in Gram-positive bacteria.
Isoniazid (INH) and ethambutol: Disrupt mycolic acid formation in mycobacteria.
Inhibition of Protein Synthesis
Overview
Antimicrobials can target bacterial ribosomes, which differ structurally from eukaryotic ribosomes, allowing selective inhibition of protein synthesis.
Drugs may interfere with the 30S or 50S ribosomal subunits, block tRNA docking, or inhibit peptide bond formation.

Major Classes of Protein Synthesis Inhibitors
Drug Class | Examples | Mode of Action | Spectrum |
|---|---|---|---|
Aminoglycosides | Gentamicin, Neomycin | Alter 30S subunit shape | Most Gram-negative, some protozoa |
Tetracyclines | Doxycycline, Tetracycline | Block tRNA docking site | Many Gram-positive/negative, Mycoplasma |
Chloramphenicol | — | Blocks peptide bond formation | Broad, rarely used |
Lincosamides | Clindamycin | Binds 50S, stops elongation | Gram-positive, anaerobic Gram-negative, protozoa |
Macrolides | Azithromycin, Erythromycin | Binds 50S, stops elongation | Gram-positive, some Gram-negative, fungi |
Oxazolidinones | Linezolid | Inhibit initiation of translation | Gram-positive bacteria |
Interference with tRNA Charging
Mupirocin: Selectively binds isoleucyl-tRNA synthetase, preventing isoleucine loading in Gram-positive bacteria.
Disruption of Cytoplasmic Membranes
Overview
Some antimicrobials disrupt membrane integrity by forming pores or interfering with sterol synthesis, leading to cell death.
Nystatin and amphotericin B: Bind ergosterol in fungal membranes, forming pores.
Polymyxin: Disrupts Gram-negative bacterial membranes.
Allylamines and azoles: Inhibit ergosterol synthesis in fungi.

Inhibition of Metabolic Pathways
Overview
Antimetabolic agents exploit differences in metabolic pathways between pathogens and hosts. They may target electron transport, enzyme activity, or folic acid synthesis.
Sulfonamides: Structural analogs of para-aminobenzoic acid (PABA), block folic acid synthesis.
Trimethoprim: Inhibits a subsequent step in folic acid synthesis.
Bedaquiline, dapsone, thiazolides: Target specific metabolic processes in mycobacteria, protozoa, and viruses.

Inhibition of Nucleic Acid Synthesis
Overview
Some drugs block DNA replication or RNA transcription, but these often affect both prokaryotic and eukaryotic cells, limiting their clinical use. They are more commonly used in research or to treat viral infections and cancer.
Quinolones/fluoroquinolones: Inhibit prokaryotic DNA gyrase.
Nucleotide/nucleoside analogs: Distort nucleic acid structure, used against viruses and cancer cells.
Rifampin: Inhibits RNA polymerase, used against Gram-positive bacteria and mycobacteria.
Prevention of Virus Attachment, Entry, or Uncoating
Overview
Antiviral drugs can block the attachment of viruses to host cells or prevent uncoating, thereby inhibiting infection.
Pleconaril: Blocks viral attachment.
Arildone: Prevents viral uncoating.
Selective Toxicity and Clinical Application
The principle of selective toxicity underlies the effectiveness of antimicrobial drugs. For example, penicillin targets cell wall synthesis, which is present in bacteria and fungi but absent in animal cells, making it selectively toxic to microbes.
Penicillin: Disrupts cell wall synthesis, leading to bacterial cell lysis.
Sulfonamides: Inhibit folic acid synthesis, blocking nucleic acid formation and microbial growth.
Example: The classic experiment showing Penicillium chrysogenum inhibiting Staphylococcus aureus growth demonstrates the selective toxicity of antibiotics.
Additional info: Selective toxicity is the foundation for the clinical use of antimicrobials, minimizing harm to the host while effectively treating infections.
